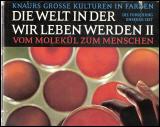

|
1000 FRAGEN an die Wissenschaft
ISBN 9783899154191 Verlag: (c) 2007 Reader s Digest Bildband gebunden 416 Seiten Format: 25,5 c... (Iu1/00091) 8,50 Euro (Kleinunternehmer im Sinne vom § 19 UStG. Es wird keine MWSt. ausgewiesen.)
|
 |

|
|
Asimov - DIE EXAKTEN GEHEIMNISSE UNSERER WELT
Titel: Die exakten Geheimnisse unserer Welt Bausteine des Lebens Autor: Isaak Asimov ISBN 3426... (Wo-4320) 6,80 Euro (Kleinunternehmer im Sinne vom § 19 UStG. Es wird keine MWSt. ausgewiesen.)
|
 |

|
|
Die WElt in der wir leben werden II
Knaurs grosse Kulturen in Farben Die Welt in der wir leben II Die Forschung unserer Zeit Vom Mole... (Su4 - 3961) 4,80 Euro (Kleinunternehmer im Sinne vom § 19 UStG. Es wird keine MWSt. ausgewiesen.)
|
 |
|
|
Gravitation - Eiführung in die Allgemeine Relativi
Titel: Gravitation - Eiführung in die Allgemeine Relativitätstheorie Autor: U.E.Schröder ISBN 9... (io15 - 5986) 5,99 Euro (Kleinunternehmer im Sinne vom § 19 UStG. Es wird keine MWSt. ausgewiesen.)
|
 |

|
|
Hoffmann Banesh - Einsteins Ideen.
Einsteins Ideen. Das Relativitätsprinzip und seine historischen Wurzeln. von: Banesh Hoffmann ... (ij13 - 10.078) 3,90 Euro (Kleinunternehmer im Sinne vom § 19 UStG. Es wird keine MWSt. ausgewiesen.)
|
 |

|
|
I. W. MITSCHURIN Ausgewählte Werke
Titel: I. W. Mitschurin Ausgewählte Werke Autor: Iwan Wladimirowitsch Mitschurin Verlag: Verlag... (Qo23-6887) 24,00 Euro (Kleinunternehmer im Sinne vom § 19 UStG. Es wird keine MWSt. ausgewiesen.)
|
 |

|
|
MENSCHENFORSCHUNG AUF NEUEN WEGEN
Titel: Menschenforschung auf neuen Wegen Autor: I. Eibl-Eibelsfeldt ISBN 3217006224 Die naturw... (Jm/3705) 3,80 Euro (Kleinunternehmer im Sinne vom § 19 UStG. Es wird keine MWSt. ausgewiesen.)
|
 |

|
|
RID HEINRICH : Bekanntschaft mit der Landschaft
Geologie erleben - mit 88 Abbildungen davon 26 in Farbe ISBN 3499167735 Autor: Heinrich Rid V... (Xo41 - 4216) 1,50 Euro (Kleinunternehmer im Sinne vom § 19 UStG. Es wird keine MWSt. ausgewiesen.)
|
 |

|
|
Thesaurus der exakten Wissenschaften
Titel: Thesaurus der exakten Wissenschaften Astrophysik - Biochemie - Chemie - Genetik - Geowiss... (Jio - 847) 15,00 Euro (Kleinunternehmer im Sinne vom § 19 UStG. Es wird keine MWSt. ausgewiesen.)
|
 |

|
|
TIME LIFE BÜCHER : Das Wachstum
Serie: Wunder der Wissenschaft Autor: James M. Tanner, Gordon Rattray Taylor Verlag: Time Life ... (Su4/003970) 2,90 Euro (Kleinunternehmer im Sinne vom § 19 UStG. Es wird keine MWSt. ausgewiesen.)
|
 |

|
|
TIME LIFE BÜCHER : Der Geist
Serie: Wunder der Wissenschaft Autor: John Rowan Wilson Verlag: Time Life 1966 Hardcover 0, 20... (Su4/3962) 2,90 Euro (Kleinunternehmer im Sinne vom § 19 UStG. Es wird keine MWSt. ausgewiesen.)
|
 |

|
|
TIME LIFE BÜCHER : Licht und Sehen
Serie: Wunder der Wissenschaft Autor: Conrad G. Mueller, Mae Rudolph Verlag: Time Life 1967 Ha... (Su4/003969) 2,90 Euro (Kleinunternehmer im Sinne vom § 19 UStG. Es wird keine MWSt. ausgewiesen.)
|
 |

|
|
TIME LIFE BÜCHER : Mensch und Organisation
Serie: Menschliches Verhalten Autor: Rafael Steinberg Verlag: Time Life 1976 Gebundene Ausgabe... (IJm-3960) 2,50 Euro (Kleinunternehmer im Sinne vom § 19 UStG. Es wird keine MWSt. ausgewiesen.)
|
 |

|
|
W. Nürnberg - Die Asynchronmaschine
Titel: Die Asynchronmaschine - Ihre Theorie und Berechnung unter besonderer Berücksichtigung der... (Qo11 - 2947 - 5434) 99,00 Euro (Kleinunternehmer im Sinne vom § 19 UStG. Es wird keine MWSt. ausgewiesen.)
|
 |

|
|
Zauber und Schönheit unserer Erde
ISBN: 3870704322 Verlag: Das Beste Readers Diggest 1992 Bildband 1, 351 Seiten Format: 23,5 x 3... (Su4/3965) 6,80 Euro (Kleinunternehmer im Sinne vom § 19 UStG. Es wird keine MWSt. ausgewiesen.)
|
 |

|
 |
 |
 |